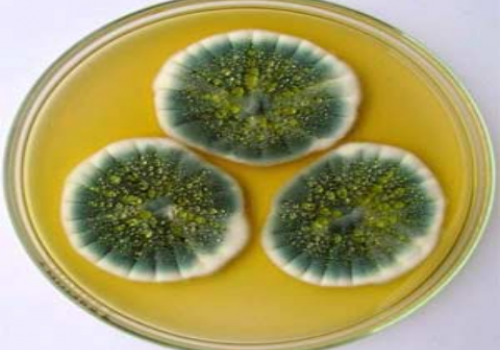
Tuyển chọn dòng Aspergillus Niger sinh tổng hợp protease hoạt tính cao

Kiến thức chuyên ngành
Xử lý bệnh đục cơ trên tôm
Đục cơ là bệnh xảy ra phổ biến trên tôm thẻ chân trắng. Bệnh có thể do nhiều nguyên ...
Xem chi tiếtXử lý ao nuôi khi khi bị đốm trắng
Bệnh đốm trắng do virus gây ra hiện chưa có biện pháp điều trị. Bởi vậy, khi ao nuôi ...
Xem chi tiếtBệnh do Vibrio parahaemolitycus trên tôm hùm
Mặc dù là tác nhân gây hội chứng chết sớm (EMS) cho tôm sú, tôm thẻ chân trắng từ ...
Xem chi tiếtGiải pháp kiểm soát bệnh do vi khuẩn Vibrio
Những năm qua, bên cạnh sự phát triển của ngành NTTS, thì dịch bệnh cũng đã gây không ít ...
Xem chi tiếtNguyên tắc “5 đúng” trong phòng và trị bệnh thủy sản
Để phòng và trị bệnh cho thủy sản nuôi hiệu quả,người nuôi trồng thủy sản nên áp dụng nguyên ...
Xem chi tiếtChủ động phòng bệnh vụ mới
Chủ động phòng bệnh luôn được xem là tiền đề, nền móng vững chắc để bước vào một vụ ...
Xem chi tiếtProtein đơn bào: Sự lựa chọn mới trong sản xuất thức ăn chăn nuôi, thủy sản
Năm 2021 mở ra một loạt sự lựa chọn mới về việc sử dụng protein đơn bào trong sản xuất thức ăn chăn nuôi và nuôi trồng thủy sản.
Xem chi tiếtỦ chua lá cọ dừa làm thức ăn cho động vật nhai lại ở Malaysia
Malaysia là một nước SX dầu cọ dừa lớn nhất thế giới. Hàng năm có tới 17 triệu tấn ...
Xem chi tiếtTuyển chọn dòng Aspergillus Niger sinh tổng hợp protease hoạt tính cao
Aspergillus Niger là dòng nấm sợi phân bố rất rộng rãi trên nhiều loại cơ chất tự nhiên và ...
Xem chi tiếtVai trò của mùi và vị trong chăn nuôi
Trong chăn nuôi, nhu cầu để duy trì là cố định, lượng thức ăn tiêu thụ vào cơ thể ...
Xem chi tiếtQuá trình lên men, ép đùn cải thiện giá trị dinh dưỡng của cám lúa mì trong khẩu phần ăn của lợn
Quá trình lên men cũng như ép đùn sẽ cải thiện giá trị dinh dưỡng của cám lúa mì. ...
Xem chi tiếtẢnh hưởng của việc bổ sung glycine, serine và threonine trong khẩu phần của gà thịt có mức protein thấp
Thức ăn gia cầm được phối trộn từ nhiều loại nguyên liệu khác nhau với thành phần các axit ...
Xem chi tiếtQuản lý EMS trên toàn thế giới
Mặc dù người nuôi tôm không còn phải quá lo sợ với EMS nữa nhưng dịch bệnh này vẫn ...
Xem chi tiếtPhòng, trị bệnh sữa ở tôm hùm
Tôm hùm là loài hải sản có giá trị dinh dưỡng, giá trị xuất khẩu cao và đang được ...
Xem chi tiếtGiám sát dịch bệnh trên tôm
Ngày 18/3/2019, Cục Thú y ban hành Công văn số 431/TY-TS hướng dẫn giám sát, điều tra và ứng ...
Xem chi tiếtPhòng bệnh cho tôm mùa nóng
Nắng nóng kéo dài sẽ ảnh hưởng không ít đến sự sinh trưởng của tôm nuôi. Người nuôi cần ...
Xem chi tiếtPhòng và xử lý EHP
Bệnh vi bào tử trùng Microsporidian trên tôm do ký sinh trùng Enterocytozoon hepatopenaei (EHP) gây
Xem chi tiếtTăng thu nhập nhờ nuôi ngỗng sư tử
Ngỗng là loài dễ nuôi, lớn nhanh, cho chất lượng thịt thơm ngon, được người tiêu dùng ưa chuộng.Tron
Xem chi tiếtĐảm bảo chất lượng thức ăn ủ chua tuyệt hảo
Thức ăn ủ chua là một phần quan trọng của khẩu phần hỗn hợp hoàn chỉnh (TMR) và là ...
Xem chi tiếtPhất lên nhờ nuôi bò sữa.
Chịu khó học hỏi, tích cực ứng dụng tiến bộ khoa học kỹ thuật trong chăn nuôi, gia đình ...
Xem chi tiếtCông ty Cổ Phần VietKo Bio
Chúng tôi luôn nỗ lực mang đến các sản phẩm, dịch vụ chất lượng tốt nhất đáp ứng sự hài lòng của quý khách hàng.
Thông tin liên hệ
Công ty Cổ Phần Vietko Bio
Địa chỉ: Số 11 đường Nguyễn Đăng, khu 2, Phường Suối Hoa , Thành phố Bắc Ninh, Tỉnh Bắc Ninh, Việt Nam
Điện thoại: 0222.652.0246
Email: info@vietkobio.com
Website: https://vietkobio.com
Bản đồ
Đăng ký nhận báo giá
Hãy đăng ký để nhận báo giá mới nhất của chúng tôi
Use of this website and the services means you agree to our Terms of Use and Privacy Policy.

.png)
.jpg)